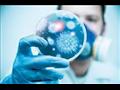
فيروس كورونا

صحة الدقهلية: شفاء 3 حالات جديدة من كورونا بمستشفى العزل بتمي الأمديد
كتب : مصراوي
فيروس كورونا
الدقهلية - رامي محمود:
ارتفعت إلى 12 حالات الشفاء بين المصابين بفيروس كورونا في مستشفى الحجر الصحى بتمى الأمديد، وذلك بعد شفاء 3 حالات بينها اثنان من أبناء محافظة القليوبية، وحالة من بني عبيد بمحافظة الدقهلية، تحول نتائج تحاليلهم من إيجابية إلى سلبية، وفق ما أعلن وكيل وزارة الصحة بالدقهلية الدكتور سعد مكي.
وأضاف مكي، في تصريحات صحفية اليوم الثلاثاء، أن باقي الحالات بمستشفى الحجر في تمي الأمديد يتلقون الرعاية الطبية الفائقة وسيتوالى خروجهم تباعًا بعد إتمام شفائهم.
يذكر أن المستشفى يضم 126 سريرًا و25 سرير رعاية مركزة، بالإضافة إلى 25 جهاز تنفس، و25 مونيتور، وأسرة حضانات في حال حدوث عمليات ولادة لأي من حالات الإصابة.